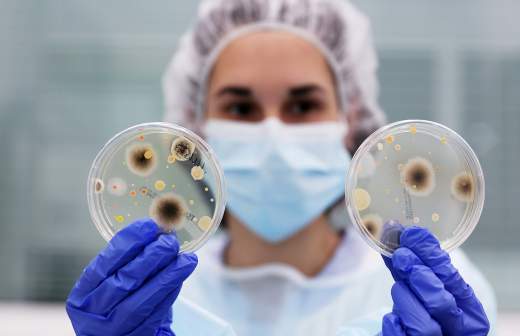

Земной уклон: создана первая карта распространения микробов в почве

Ученые из Ростова-на-Дону создали первую в России онлайн-карту микробного разнообразия в почве. На ней можно увидеть, к какому типу относится тот или иной участок земли, какие микроорганизмы там обитают, устойчивы ли они к антибиотикам. Данные важны для поиска наиболее плодородного чернозема, зараженных участков, оценки экологической ситуации и результатов воздействия человека на окружающую среду. На данном этапе исследована территория Ростовской области, но в дальнейшем такие карты можно составить и для других регионов страны. Работа ученых, помимо прочего, поможет создавать биопрепараты для повышения плодородия почв и иммунитета выращиваемых там растений, говорят эксперты.
Кто обитает на дне чернозема
Ученые Южного федерального университета (ЮФУ) разработали «Карту метагенома Ростовской области» (метагеном — набор генов всех организмов в изучаемой среде. — «Известия»). Она визуализирует распределения микробов в зависимости от типа и происхождения почв, степени активности хозяйственной деятельности человека. По сути, это индикатор «здоровья» и качества чернозема на каждом конкретном участке местности. Для почв Юга России такое исследование проведено впервые. Аналогов данной онлайн-карте нет ни в России, ни в мире, заявили «Известиям» разработчики.
На первом этапе специалисты изучили метагеном почв особо охраняемых природных территорий Ростовской области с высоким уровнем плодородия. Затем сотрудники академии биологии и биотехнологии Д.И. Ивановского ЮФУ выделили представленные там сочетания микробов и на основе полученных данных исследовали другие территории региона.
— Использование современных методов метагеномики даст возможность изучить все разнообразие и функции почвенного микробиома, так как в настоящее время он изучен максимум на 5%, — рассказала руководитель стратегического проекта ЮФУ «Управление почвенными ресурсами и агроклиматология», заведующая кафедрой почвоведения и оценки земельных ресурсов АБИБ ЮФУ Татьяна Минкина.
Доступ к порталу уже открыт. Для отображения информации о почве достаточно нажать кнопкой мыши на интересующий участок цифровой карты. Так можно будет узнать все необходимые сведения о типе земли и сообществе обитающих в ней микроорганизмов. На сайте есть и поиск по названию филума (рода) той или иной бактерии. Выбрав его в таблице, можно увидеть, где и в каком количестве обитает этот микроб. В дальнейшем такие карты можно будет сделать и для других регионов страны.
Микробы разные нужны
Исследование показало, что земли, практически не подверженные влиянию человека, обладают наибольшим биоразнообразием по сравнению с активно использующимися в сельском хозяйстве, и могут служить эталонами качества почв. По словам ученых ЮФУ, выделение подобных эталонов имеет стратегическое значение для устойчивого развития как ландшафтных, так и сельскохозяйственных территорий.
— Мы не только диагностируем те изменения, которые происходят в природе, но также разрабатываем прорывные технологии для сохранения природно-ресурсного потенциала Юга России. Используя высокотехнологичный метод метагеномного секвенирования ДНК (прочтения генетического когда всей совокупности микроорганизмов. — «Известия»), мы можем разрабатывать биопрепараты для повышения плодородия почв, — рассказал доцент кафедры биохимии и микробиологии ЮФУ Андрей Горовцев.
Также карта поможет выбрать подходящий препарат для «лечения» гумуса в случае заражения. Ведь помимо прочего, ученые оценили количество и спектр генов антибиотикоустойчивости в почвах. В пробах почв ученые нашли 56 таких уникальных участков, обеспечивающих резистентность к двум и более различным типам антибиотиков. Разработанная карта поможет специалистам узнать, какие именно вещества не работают, и подобрать наиболее эффективные составы.
Важно и то, что микроорганизмы почвы тесно связаны с растениями, которые на ней растут. Описан широкий спектр видов грибов и бактерий, стимулирующих рост и укрепляющих иммунитет растений, сообщила «Известиям» доцент агробиотехнологического департамента АТИ РУДН Елена Чудинова. Например, некоторые из них способны подавлять рост патогенной микробиоты.
— В настоящее время активно применяются биопрепараты на основе полезных видов микроорганизмов, — рассказала она. — Работа, выполненная коллегами из ЮФУ, позволит оценить состояние почвенной микробиоты, внести необходимую корректировку в технологию выращивания сельскохозяйственных растений. Полученные данные также важны для исследований влияния антропогенного фактора на биоразнообразие.
Полученные результаты имеют как фундаментальное значение, связанное с изучением адаптации и эволюции микробного сообщества почв, так и практическое — специалисты смогут выработать микробные корреляты здоровья и плодородия почв, уверены ученые.
Специалисты ЮФУ развивают технологии защиты почвы в рамках реализации стратегического проекта «Управление почвенными ресурсами и агроклиматология» по программе Минобрнауки «Приоритет 2030» (нацпроект «Наука и университеты»).